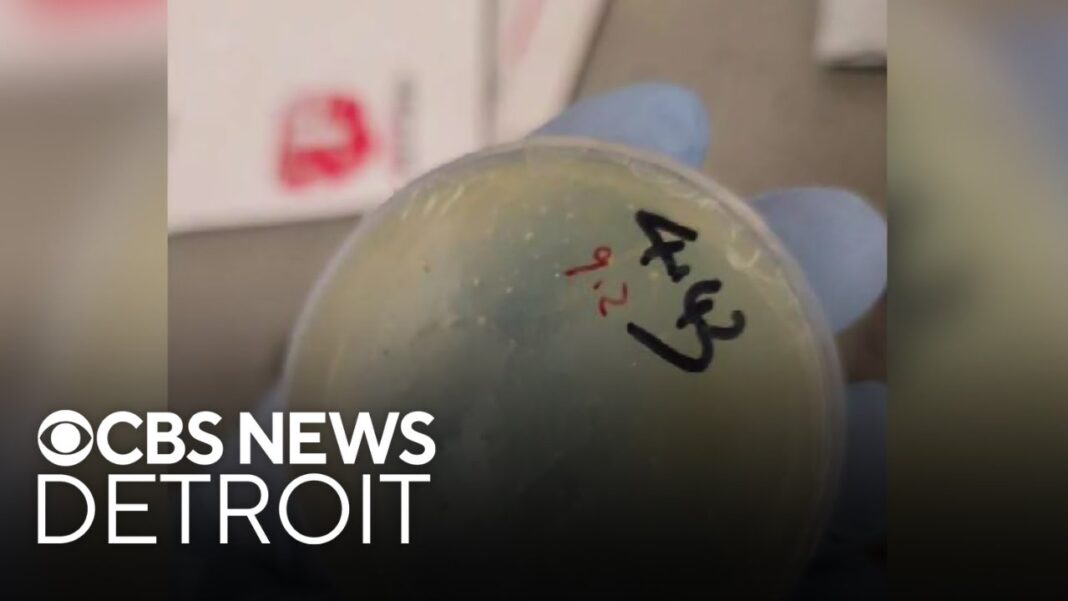

A California police department was the first. Hundreds followed. Many laud success stories while some raise privacy concerns.
CHULA VISTA, Calif.—The scene that unfolded along Interstate 5 looked like a carefully choreographed action-film sequence. But it was a real life-or-death situation.
Flames and smoke billowed into the night sky from a vehicle that had crashed off the roadway. Upon arrival, police discovered that the car’s driver was trapped inside, screaming in agony.
“C’mon, give me your hand!” an officer yelled, as he and three others worked frantically to extricate the man through a rear window they had broken.
Panting and grunting, the officers struggled. Then, seconds after they pulled the man to safety along the highway’s berm, the car exploded. A ball of fire engulfed it—just as a fire truck arrived.
The Hollywood-worthy timing, captured on video, is breathtaking.
“That guy probably would have perished,” Chula Vista Police Capt. John English said, if not for the officers’ heroism—and the aid of a camera-equipped, airborne drone.
By relaying real-time information to officers as they head to emergencies such as this one, drones help police plan their actions.
English reviewed video of the fiery rescue with The Epoch Times, explaining how a drone helped officers save the man’s life.
As the car burned, the drone’s aerial view allowed police to quickly identify the best route to the scene. Without that perspective, officers easily could have chosen a more distant highway entrance. “That would have taken extra time to get there—and they didn’t have it,” English said.
Also, because the drone’s thermal imaging showed no person near the burning car, officers suspected someone might still be inside the wreckage. That fear increased their sense of urgency, helping to avert tragedy.
Although the man and three of the four rescuing officers were hurt, all recovered. That incident, on Oct. 13, 2023, stands out as a dramatic example of how drones are bolstering police work across the nation.
Officers have used terms such as “game-changer,” “transformational,” and “revolutionary” to describe the impact of drones on their jobs.
Others are raising alarms over this technology’s capability to be intrusive.
By Janice Hisle